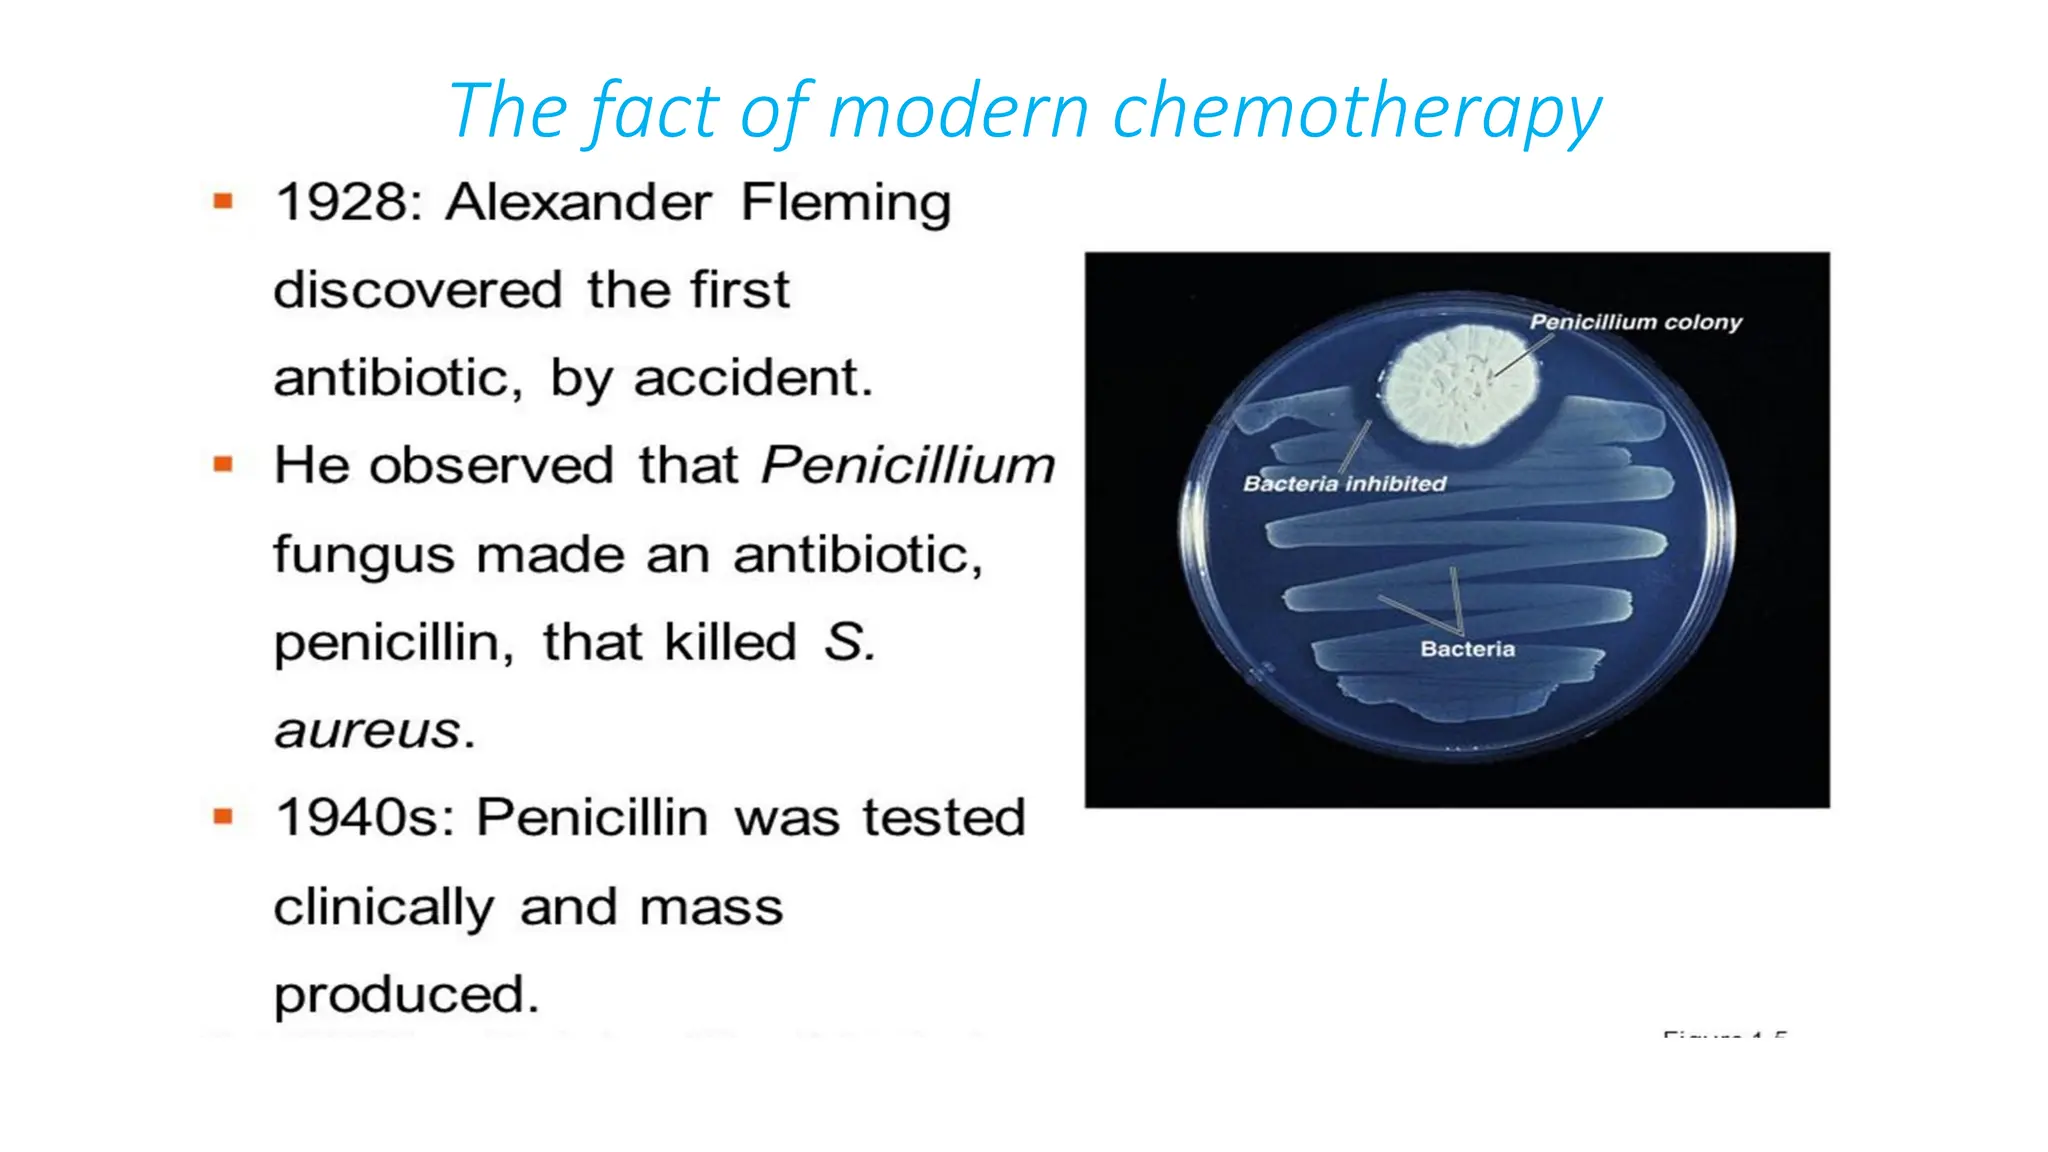
The fact of modern chemotherapy

The document outlines the curriculum for a general microbiology lecture covering historical insights, laboratory safety measures, methods for clinical sample collection, and the importance of studying microbiology. It details established scientific theories, such as germ theory and Koch's postulates, and highlights significant microorganisms and laboratory equipment. Additionally, it provides guidelines for proper specimen handling and emphasizes the significance of understanding microbial flora in relation to human health.